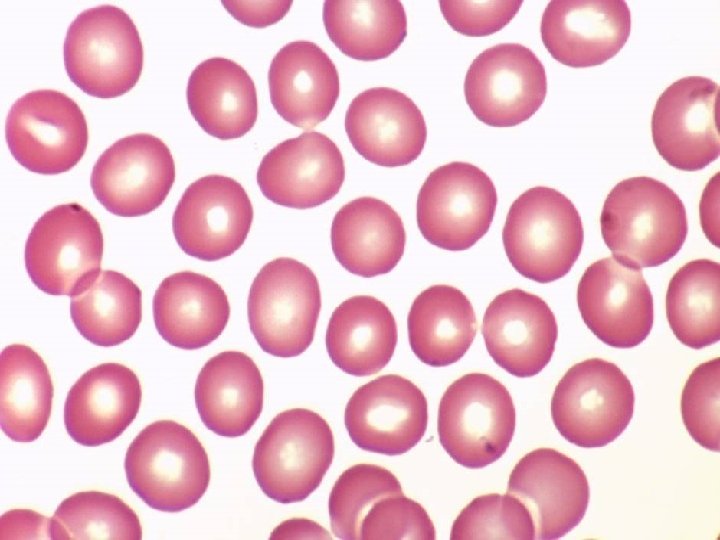
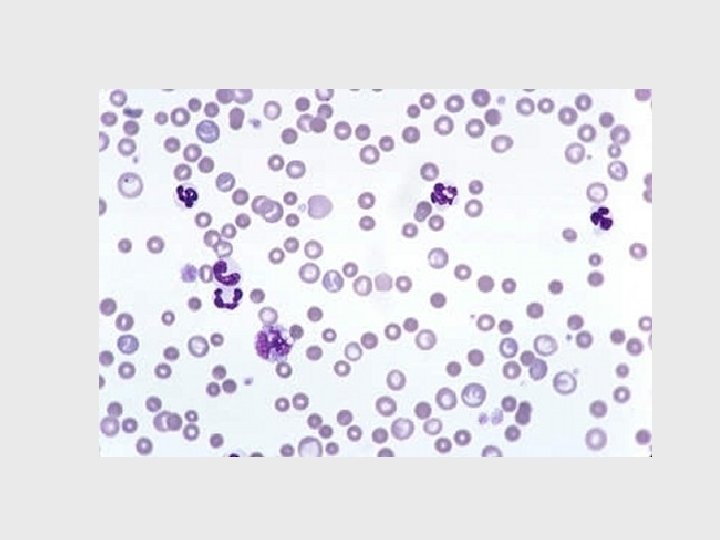

THE CIRCULATORY SYSTEM What is the circulatory system

- Slides: 75
THE CIRCULATORY SYSTEM
What is the circulatory system? Ø The circulatory system carries blood and dissolved substances to and from different places in the body. Ø The Heart has the job of pumping these around the body. Ø The Heart pumps blood and substances around the body in tubes called blood vessels. Ø The Heart and blood vessels together make up the Circulatory System.
Functions of the circulatory system: Distribute nutrients, Transport and exchange oxygen and carbon dioxide, Remove waste materials, Distribute secretions of endocrine glands,
Prevent excessive bleeding, Prevent infection, and Regulate body temperature.
blood from the heart gets around the body through blood vessels There are 3 types of blood vessels a. ARTERY b. VEIN c. CAPILLARY
The ARTERY Arteries carry blood away from the heart. the elastic fibres allow the artery to stretch under pressure thick muscle and elastic fibres the thick muscle can contract to push the blood along.
Arteries • These carry oxygenated blood away from the heart • The only exception is the pulmonary artery, which carries deoxygenated blood from the heart to the lungs • Arteries do not have valves • Blood is bright red in colour • Blood pressure is taken from here
The VEIN Veins carry blood towards from the heart. veins have valves which act to stop the blood from going in the wrong direction. thin muscle and elastic fibres
Veins • At any time approximately 50 percent of blood volume will be present in veins • They are thinner and less elastic than arteries veins have valves to prevent back flow • Their function is to transport blood to the heart to obtain oxygen • Blood is dark red in colour • Blood samples are taken from here • Veins have valves
The CAPILLARY Capillaries link Arteries with Veins they exchange materials between the blood and other body cells. the wall of a capillary is only one cell thick Carry oxygenated and deoxygenated blood
The CAPILLARY A collection of capillaries is known as a capillary bed artery body cell vein capillaries
Venepuncture • Blood Collection Sites • The most common sites to take blood samples from are: – the jugular vein , – cephalic vein, – saphenous vein. The locations of the veins are the same in every dog and cat. .
Blood Sample Sites
Jugular Samples • The jugular vein is the prominent vessel on the front of your neck. • There is one jugular vein on each side of the trachea (windpipe). • The anatomy is the same in people, dogs, cats, horses, cows, and lots of other animals. • Jugular veins drain blood from the head down to the heart. • It also pops up if you press your finger into the bottom of the groove beside the
Jugular Sample
https: //www. youtube. com/watch ? v=SOE 8 -0 r. ZGd. E
Cephalic vein • The cephalic vein is located on the front of the foreleg • The vein runs under the skin between the carpal (wrist) joint and the elbow.
https: //www. youtube. com/watch ? v=cb. Tf 0 NLQOe. A
Saphenous Vein • You'll find this particular vein on the hind leg. It runs on the outside (lateral) surface just above the hock (ankle).
https: //www. youtube. com/watch ? v=c. KF-mzoabb 8
Pulse sites - Arteries • There are several areas on the dog's body where you may be able to feel the pulse. • • • Sublingual Carpal Femoral Coccygeal Carotid Tarsal
Sublingual • Found under tongue • Usually used to monitor pulse when patient is under anaesthesia
Carpal Artery • Found in foreleg • Palmar aspect of carpus • Common site to take pulse
Femoral artery • Found in the inner thigh (hind limb) • Place the ball of one or two fingers over this artery on the inside ( groin area) of your dog's thigh.
Coccygeal artery • Ventral aspect of tail base
Carotid Artery • Found in neck
Tarsal Artery • Found hind leg ankle • Medial tarsal
How does the circulatory system work?
The circulatory system • Comprised of the heart and blood vessels. • The heart is a muscular organ in your chest that pumps blood through your veins , arteries and capillaries ( these make up the circulatory system).
Anatomy and Physiology of the Heart The heart is a funnel-shaped, hollow, muscular organ that is responsible for pumping blood to all parts of the body. The heart is located near the center of the chest (thoracic cavity) between the lungs One side of the heart deals with OXYGENATED BLOOD One side of the heart deals with DEOXYGENATED BLOOD
The 4 chambers of the heart
Our circulatory system is a double circulatory system. This means it has two parts. Lungs the right side of the left side of the system deals with oxygenated blood. deoxygenated blood. Body cells
Heart Valves
How does blood not flow back into the heart? • There are valves placed within the heart to prevent blood flow back Right Atrioventricular valve Left Atrioventricular valve
Atrioventricular valves can also be named: Tricuspid valve - right Bicuspid valve – left
Other Valves: This is to prevent backflow from blood vessels to ventricle Semilunar valves Aortic – left Pulmonary - right
Anatomy of the heart and vessels
Structure and functions of the heart Pericardium Epicardium the inner serous layer of the pericardium Myocardium Muscle of the heart Endocardium The endocardium is the innermost layer of heart tissue Atria two upper chambers of the heart Ventricle 2 lower chambers of the heart Atrio ventricular valves Valves that prevent back flow of blood from the ventricle to the atrium Semi lunar valves Valves that prevent backflow of blood from the vessel to the ventricle Papillary muscle A small muscle within the heart that anchors the heart valves Chordae Tendinae cord-like tendons that connect the papillary muscles to the valves Septum The dividing wall between the right and left sides of the heart Vena cava a large vein carrying deoxygenated blood into the heart Aorta the main artery of the body, supplying oxygenated blood to the circulatory system. Coronary vessels Help supply the heart with blood The pericardium is a membrane, or sac, that surrounds your heart. It holds the heart in place and helps it work properly. Pulmonary artery the artery carrying blood from the right ventricle of the heart to the lungs for oxygenation. Pulmonary Vein Carries oxygenated blood to the heart
Heart Structure
How does the Heart work? STEP ONE blood from the body blood from the lungs The heart beat begins when the heart muscles relax and blood flows into the atria.
How does the Heart work? STEP TWO The atria then contract and the valves open to allow blood into the ventricles.
How does the Heart work? STEP THREE The valves close to stop blood flowing backwards. The ventricles contract forcing the blood to leave the heart. At the same time, the atria are relaxing and once again filling with blood. The cycle then repeats itself.
SUMMARY copy and complete the following; Arteries take blood ______ from the heart. The walls of an artery are made up of thick _____ walls and elastic fibres. Veins carry blood ____ the heart and also have valves. The _____ link arteries and veins, and have a one cell thick wall. Blood is made up of four main things ______, the liquid part of the blood; Red Blood Cells to carry ______; White Blood cells to protect the body from disease and _____ to help blood clot.
SUMMARY copy and complete the following; away from the heart. The walls of an artery Arteries take blood ______ muscular walls and elastic fibres. Veins carry are made up of thick _____ towards blood ____ the heart and also have valves. The _____ link capillaries arteries and veins, and have a one cell thick wall. Blood is made up of plasma four main things ______, the liquid part of the blood; Red Blood oxygen Cells to carry ______; White Blood cells to protect the body from platelets disease and _____ to help blood clot.
What is blood
what’s in digested food red blood cells white blood cells oxygen waste (urea) platelets carbon dioxide plasma hormones
The Blood red blood cell platelets white blood cell plasma
Plasma It also contains useful things like; • glucose • amino acids Fluid part of blood. Contains movement for blood cells • proteins • minerals • vitamins • hormones • waste materials like urea.
Buffy Coat Contains: • Platelets – Also known as thrombocytes • White blood cells- also known as leucocytes
Red Blood Cells (RBC) – Also known as Erythrocytes
Blood • The use of blood within the veterinary environment
What types of vessels would we use to gain a blood sample?
Name of veins that could be used to take blood samples
Blood Microscopy Red Blood Cells (Erythrocytes) White Blood Cells ( Leucocytes) Platelets (Thrombocytes)
Red Blood Cells a biconcave disc that is round and flat without a nucleus contain haemoglobin, a molecule specially designed to hold oxygen and carry it to cells that need it. can change shape to an amazing extent, without breaking, as it squeezes single file through the capillaries.
Aneamia is a condition caused by low levels of red blood cells and hemoglobin. Aneamia can be caused by the following: • Loss of blood due to injury, • Infestations of blood-sucking parasites, or • Low levels of red cell production due to poor nutrition.
White Blood Cells there are 2 groups of white blood cells. all white blood cells contain a nucleus.
Granulocytes are the category of leukocytes that contain granules within the cytoplasm. Granulocytes include:
Neutrophils • produced by bone marrow, • neutrophils fight disease by migrating to the point of infection, absorbing (phagocytosis ) bacteria, and destroying them, resulting in a semi-liquid material called pus. • Abscess – a concentrated area of pus.
Basophils – rare granulocytes that are responsible for the symptoms of allergies, including inflammation. Basophils
Eosinophils - • a type of granulocyte that plays a role in combating infection by parasites, as well as, impacting allergies and asthma. • They contain most of the histamine which causes inflammation Images courtesy of Wikipedia.
White Blood Cells there are 2 groups of white blood cells. all white blood cells contain a nucleus.
Agranulocytes are the category of leucocytes that contain very little, if any, granules. Agranulocytes are produced by the lymph nodes, spleen, thymus, and other lymphoid tissue.
Lymphocytes – • Produce and release antibodies at site of infections to fight disease • Lymphocytes also produce antibodies that allow an animal to build up immunities to a particular disease. B Lymphocyte T Lymphocytes
Two types of Lymphocytes • There are 2 types of lymphocyte - produced in the bone marrow before birth. • B lymphocytes, also called B cells, stay within the bone marrow until they are mature. Once mature, they spread throughout the body and concentrate in the spleen and lymph nodes. • T lymphocytes, or T cells, leave the bone marrow and mature in the thymus, a gland found in the chest. Only mature lymphocytes can carry out immune responses
Macrophages – Adult Monocyte • Macrophages are important cells of the immune system that are formed in response to an infection or accumulating damaged or dead cells. • Macrophages are large, specialized cells that recognize, engulf and destroy target cells. • The term macrophage is formed by the combination of the Greek terms "makro" meaning big and "phagein" meaning eat.
• Unlike neutrophils, monocytes do not produce pus. Image courtesy of Wikipedia.
Platelets produce tiny fibrinogen fibres to form a net. This net traps other blood cells to form a blood clot.
Blood clotting is called coagulation and is important in reducing blood loss caused by injury and in healing the injury.
How does this system work? pulmonary vein pulmonary artery lungs head & arms Pulmonary Artery aorta Vena cava main vein Pulmonary Veins Right Left liver digestive system kidneys legs Circulatory System